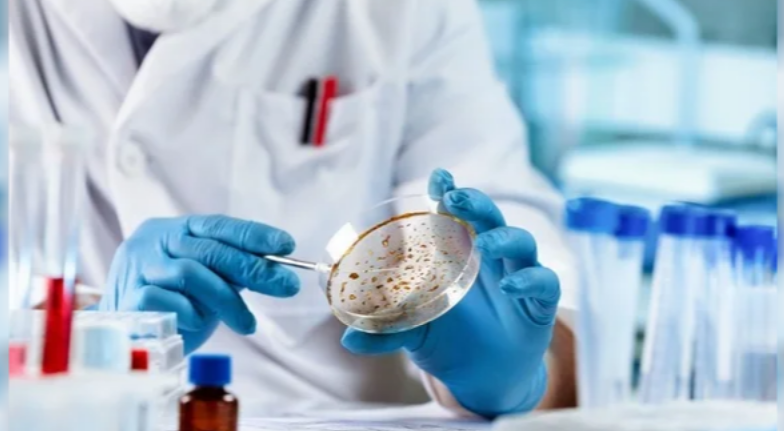

Investigadores del Instituto Hudson de Investigación Médica, en Australia, presentaron un recurso científico que podría transformar el abordaje del cáncer infantil: el Atlas del Modelo de Cáncer Infantil (CCMA), la base de datos más grande del mundo con más de 400 líneas celulares de tumores pediátricos de alto riesgo.
El catálogo, diseñado especialmente para pruebas impulsadas por Inteligencia Artificial (IA), busca acelerar el descubrimiento de biomarcadores y el desarrollo de inmunoterapias adaptadas a las necesidades de los pacientes más jóvenes. Las terapias actuales, basadas mayormente en modelos adultos, muchas veces resultan poco efectivas en niños y pueden generar efectos secundarios duraderos en sus organismos en crecimiento.
Lee: Telemedicina de Iapos: destacan que la herramienta promueve la consulta temprana y preventiva
Los científicos analizaron más de 200 líneas celulares del CCMA para evaluar dos factores clave del reconocimiento inmunológico: el tipo de HLA (Antígenos Leucocitarios Humanos) y los potenciales neoantígenos que cada tumor es capaz de presentar al sistema inmune.
La investigadora Claire Xin Sun, autora principal del estudio publicado en la revista iScience, destacó la relevancia del hallazgo:
«Los HLA son proteínas en la superficie de las células que el sistema inmunitario utiliza para distinguir entre lo propio y lo ajeno. Con esta información, predijimos qué neoantígenos podría producir y presentar cada modelo de cáncer».
Los neoantígenos —pequeños fragmentos proteicos anormales generados por mutaciones tumorales— son considerados una pieza central en el diseño de terapias que ayuden al organismo a identificar y atacar de manera más efectiva a las células malignas. Conocer el tipo de HLA resulta fundamental para determinar qué neoantígenos pueden ser detectados por el sistema inmunológico.
Mira: Argentina marca un hito médico: primer autotrasplante ovárico asistido por robot en el país
El estudio permitirá definir qué tumores poseen antígenos procesables y, por lo tanto, son candidatos ideales para nuevos tratamientos de inmunoterapia. El objetivo final: impulsar terapias más seguras, certeras y adaptadas a la biología particular de los pacientes pediátricos.
El avance representa una herramienta científica de alcance global y un paso significativo en la lucha contra una de las principales causas de muerte por enfermedad en la infancia.





